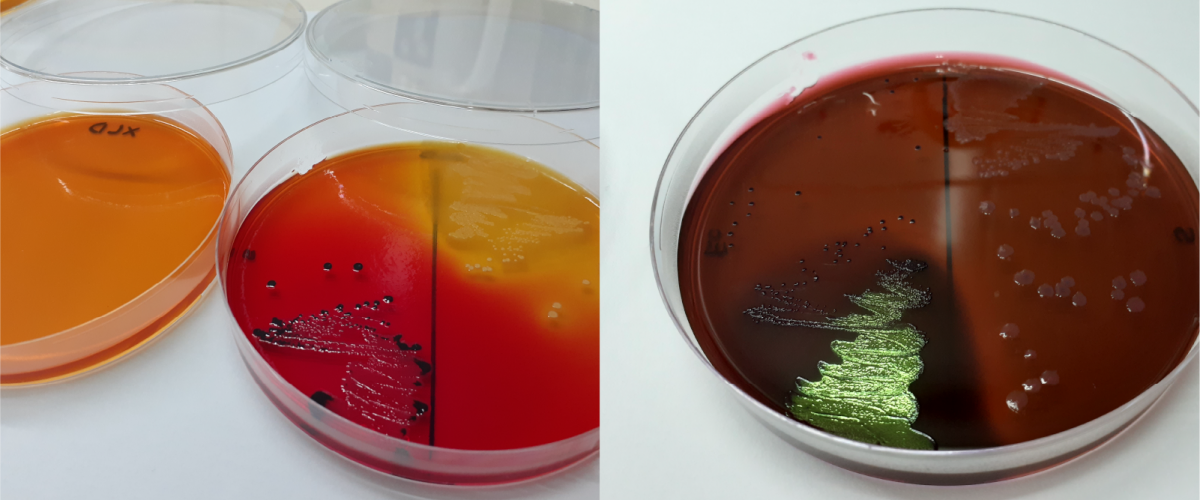
Análisis de Materias Primas, Alimentos e Ingredientes

1. Análisis Composicional y de control rutinario:
- Macronutrientes: proteínas, cenizas, grasa, almidón total, nitrógeno no proteico, hidratos de carbono total, azúcares reductores, fibra dietaria total, fibra soluble, fibra insoluble, mono- y disacáridos.
- Minerales: Na, K, Ca, Mg, Cu, Fe, Zn y P.
- Sólidos: totales, solubles, acidez titulable y pH.
- Compuestos bioactivos: fenólicos totales (libres y ligados), antocianinas totales, ácido fítico, perfil de compuestos fenólicos.
- Proteínas: perfil de aminoácidos, peso molecular de proteínas y péptidos, digestibilidad proteica.
- Lípidos: triglicéridos y colesterol.
- Vitaminas y pigmentos: Vitamina C, carotenoides totales, betalaínas.
- Conservantes: ácido sórbico y ácido benzoico.
2. Propiedades Funcionales y relacionadas a la vida útil:
- Harinas: granulometría, actividad enzimática y calidad de gluten.
- Semillas: medida de tasa de germinación (prueba tetrazolio).
- Bioaccesibilidad: disponibilidad in vitro de minerales (Fe, Zn, Ca, Cu, Mg).
- Sistemas dispersos: propiedades emulsionantes, espumantes, gelificación, micro- y nanoparticulación.
- Estabilidad: evaluación de sinéresis en condiciones normales y aceleradas.
- Hidratación: absorción de agua, solubilidad y dispersibilidad proteica.
- Productos elaborados: análisis de extrudidos (expansión, textura) y pastas (tiempo de cocción, pérdida de sólidos).
- Hidrólisis: grado de hidrólisis (GH) por OPA y pH-stat.
- Nanotecnología: caracterización de tamaño, potencial zeta y polidispersidad.
- Fisicoquímica avanzada: actividad de agua (AquaLab), color (Minolta), índice de refracción, °Brix.
- Textura: propiedades mecánicas (TXA Food Texture Analyser), firmeza, dureza, perfil TPA, tracción y corte.
- Interfases y Reología: tensión superficial dinámica, concentración micelar crítica, ángulo de contacto y parámetros reológicos (viscosidad, curvas de flujo).
- Oxidación y Bioactividad: TBARS, índice de peróxidos, propiedades antioxidantes y antihipertensivas.
- Sensorial: evaluación sensorial y estudios sobre ciencias del consumidor.
- Vida útil: estabilidad de agentes bioactivos y evaluación en distintas condiciones (T°, humedad, iluminación).
3. Análisis Microbiológico:
- Metodología Oficial: microorganismos indicadores.
- Vida útil: análisis microbiológicos específicos.
- Inocuidad: detección de bacterias patógenas (ETA) según el Código Alimentario Argentino.
- Industria: microorganismos alterantes y de interés tecnológico.
- Validación: procesos de inocuidad y pruebas de desafío (challenge tests).
4. Análisis Enzimático y Bioquímico:
- Actividades enzimáticas: catalasa, glutatión reductasa, β-glucosidasa, β-glucuronidasa, mucinasa.
- Estrés oxidativo: glutatión reducido y oxidado (GSH/GSSG), glutatión reductasa y peroxidasa.
- Calidad vegetal: enzimas polifenoloxidasa (PPO) y peroxidasa (POD).